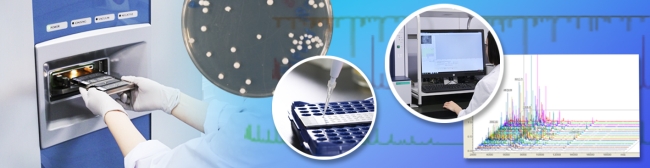

微生物のMALDI-TOF MS実測データの提供
(細菌591種・真菌168種)
微生物のMALDI-TOF MS実測データの提供
【お知らせ】真菌168種のMALDI-TOF MS実測データを新規公開しました(2026.5.20)
株式会社島津製作所、国立研究開発法人産業技術総合研究所とNITEの三者の連携事業で得られた、細菌591種、真菌168種のMALDI-TOF MS実測データを、テキスト形式のマススペクトルデータ(以下「本データ」という。)として、提供しています。
菌種や株番号などの情報は以下リンクのリストをご覧ください。
細菌591種の微生物株リスト【Excel:50KB】(2026.5.20リスト更新)
真菌168種の微生物株リスト【Excel:58KB】(2026.5.20新規公開)
以下の免責事項に同意のうえ、ぜひご活用ください。
本データは【データのダウンロードはこちら】下部のアイコンからご利用いただけます。
免責事項
本データのご利用にあたっては、下記の免責事項をよくお読みいただき、ご了承のうえお使いください。
1. 本データは独立行政法人製品技術評価技術基盤機構(以下「機構」という。)及び株式会社島津製作所(以下「島津」という。)が取得したマススペクトルデータです。
2. 機構は本データの利用者の以下の行為を禁止します。
(1) 本データを用いての医療行為。
(2) 本データの第三者へ再配布。
3. 機構、島津、MALDI-TOF MS微生物同定システムの製造者及びサプライヤーは、利用者が本ライブラリーの情報を用いて行う一切の行為及びその結果について、何ら責任を負いません。
4. 利用者は、本データの使用に伴い直接又は間接に発生するあらゆる請求、訴訟、責任、費用及び支出において、機構、分析機器及びソフトウェアの、製造者及びその役員、従業員、代理人を免責補償するものとします。
5. 本データの使用における全ての問い合わせは、利用者が機構に行うものとします。
6. 機構は、予告なしに本データの内容を変更または削除することがあります。
【データのダウンロードはこちら】
株式会社島津製作所、国立研究開発法人産業技術総合研究所との連携事業概要
NITEは、株式会社島津製作所、国立研究開発法人産業技術総合研究所と三者で連携し、従来のMALDI-TOF MSを用いた微生物同定の課題解決に向けて取り組んできました。その成果のひとつとして、原核微生物を対象とした次世代のMALDI-TOF MS微生物同定ソフトウェアの開発、製品化がなされました。
株式会社島津製作所プレスリリースページ
本ソフトウェアでは、ゲノム情報に含まれる遺伝子からその微生物が生成するタンパク質の理論質量を算出したデータベースを用いており、未培養や難培養の微生物も含めた約85,000種の原核微生物を網羅しています。MALDI-TOF MSのメーカーや機種に依存せず微生物の培養条件にも左右されずに同定が可能です。
NITEは、実測データの取得や同定結果の妥当性の評価などにより、この開発と製品化に貢献しました。
お問い合わせ
- 独立行政法人製品評価技術基盤機構 バイオテクノロジーセンター バイオ技術評価・開発課(かずさ)
-
TEL:0438-20-5764
住所:〒292-0818 千葉県木更津市かずさ鎌足2-5-8 地図
お問い合わせフォームへ










